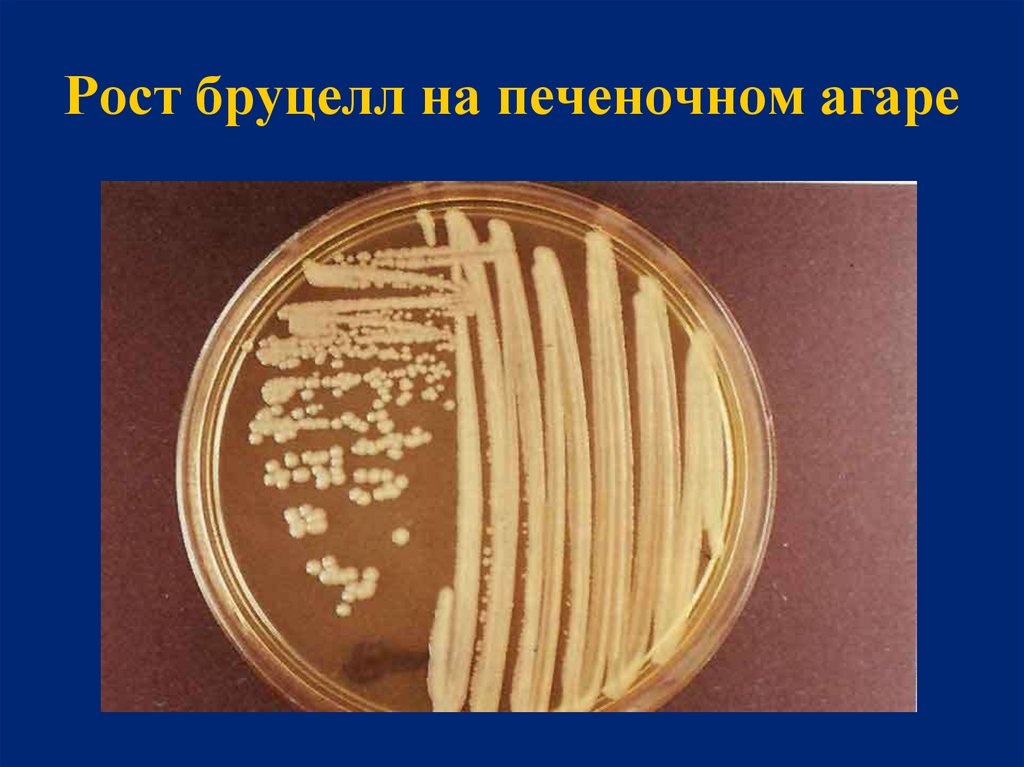
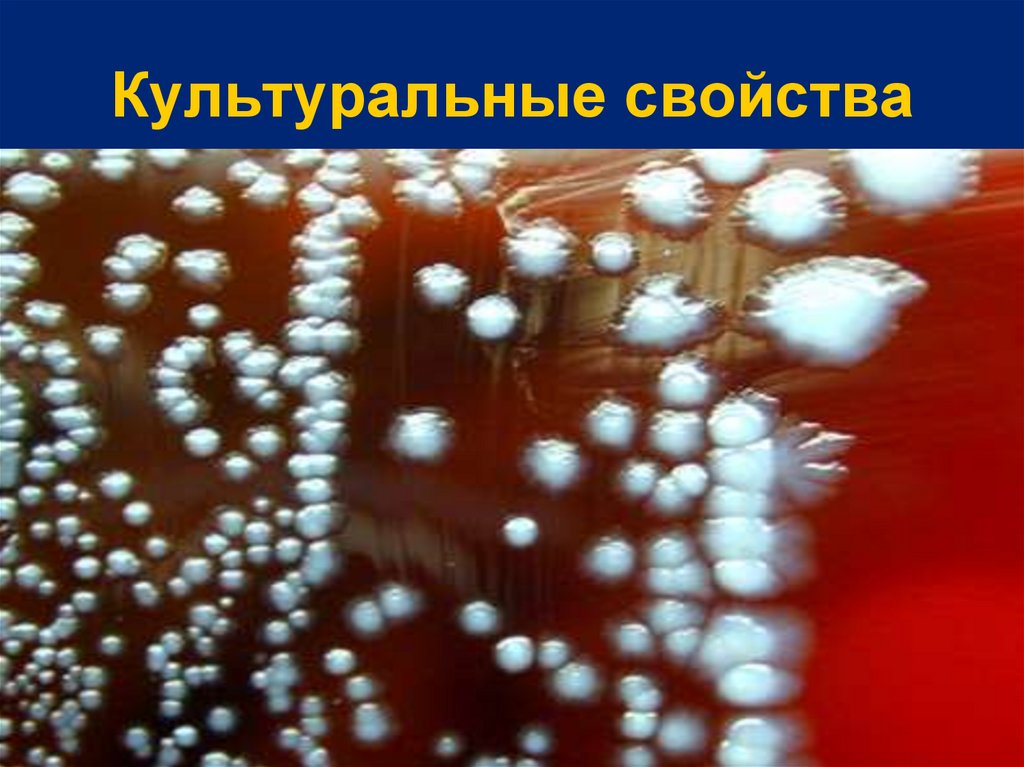

Similar presentations:
Бруцеллез. Чума. Туляремия
1. Бруцеллез. Чума. Туляремия.
УРАЛЬСКИЙ ГОСУДАРСТВЕННЫЙ МЕДИЦИНСКИЙ УНИВЕРСИТЕТКАФЕДРА МИКРОБИОЛОГИИ, ВИРУСОЛОГИИ И ИММУНОЛОГИИ
Бруцеллез.
Чума. Туляремия.
2. Бруцеллез
3.
Бруцеллез - (мальтийскаялихорадка, лихорадка Кипра,
волнообразная лихорадка,
ундулирующая лихорадка) – это
острое инфекционноаллергическое зоонозное
заболевание, вызываемое
бактериями рода Brucella.
4.
У человека бруцеллез проявляетсяпоражением опорно-двигательной,
нервной и половой систем,
сопровождается, как правило,
хронизацией инфекционного процесса
и инвалидизацией больного.
У животных бруцеллез чаще всего
протекает в латентной форме и
проявляется абортами.
5. Возбудитель бруцеллеза впервые обнаружил в 1886 г. английский военный врач и паразитолог сэр Дэвид Брюс
6.
Семейство BrucellaceaeРод Brucella
Виды бруцелл:
B. melitensis - возбудитель бруцеллеза мелкого
рогатого скота (овец, коз)
B. abortus - возбудитель бруцеллеза крупного
рогатого скота
B. suis - возбудитель бруцеллеза свиней
B. ovis - возбудитель инфекционного аборта
овец
7. Биологические свойства
Бруцеллы являются мелкимипалочковидными (0,3-0,6 мкм)
грамотрицательными бактериям
Неподвижны
Спор не образуют
Строгие аэробы
8. Сканирующая микроскопия
9. Окраска по Граму
10. Культуральные свойства
Для культивирования используют среды сдобавлением крови, сыворотки крови, глюкозы,
глицерина: кровяной агар, мясо-пептонный
печеночный бульон, печеночно-глюкозноглицериновый бульон, печеночно-глюкозноглицериновый агар.
На плотных питательных средах вирулентные
штаммы бруцелл образуют блестящие округлые
гладкие мелкие (2-3 мм) колонии
Sформы, авирулентные штаммы формируют
колонии R-формы.
11. Рост бруцелл на печеночном агаре
12. Резистентность
Бруцеллы устойчивы в окружающей среде.Сохраняются:
во влажной почве и воде до 4,5 месяцев,
в молоке - до 273 дней,
в масле – до 142 дней,
в сыре - до 1 года,
в замороженном мясе – до 60 дней
в шерсти - до 3-4 месяцев.
При кипячении погибают через несколько
секунд.
13.
Источником инфекции - являются больныеживотные (овцы, козы, коровы, свиньи, реже собаки), выделяющие бруцеллы при аборте и родах,
с мочой, калом, молоком.
Заболевания людей возникают на фоне эпизоотий.
Человек является вторичным хозяином для
бруцелл.
Больные люди не являются источником инфекции
для человека.
Заболеваемость людей бруцеллезом носит
профессиональный характер.
Пути передачи:
• алиментарный,
• контактно-бытовой,
• воздушно-капельный.
14.
Бруцеллы - факультативныевнутриклеточные паразиты.
Они живут и размножаются
преимущественно внутри клеток
ретикулоэндотелиальной системы
зараженного организма.
Факторы патогенности:
микрокапсула,
эндотоксин.
ферменты агрессии - гиалуронидаза,
нейраминидаза, каталаза, уреаза,
белки наружной мембраны.
15.
Входными воротами при бруцеллезе служатмикротравмы кожи и слизистые оболочки
желудочно-кишечного тракта, дыхательных путей и
конъюнктива.
В месте входных ворот инфекции патологические
изменения отсутствуют.
Из входных ворот бруцеллы переносятся по
лимфатическим путям в региональные
лимфатические узлы, где поглощаются
макрофагами.
В течение первых 5-10 суток бруцеллы усиленно
размножаются в макрофагах регионарных
лимфатических узлов.
16.
Лимфатические узлы превращаются всвоеобразные “депо” бруцелл.
Из лимфатических узлов возбудитель
периодически проникает в кровь и
распространяется по всему организму,
избирательно поражая ткани
ретикулоэндотелиальной системы – печень,
селезенку, костный мозг.
В этих органах бруцеллы внутри клеток
сохраняются длительное время, а при
обострении процесса вновь попадают в кровь,
вызывая рецидив.
17.
Проникновение бруцелл в кровьсопровождается генерализацией инфекции и
бактериемией, которая сохраняется в течение
длительного времени (1-3 года).
При попадании в кровь часть бруцелл
погибает, высвобождая эндотоксин.
В результате этого происходит интоксикация
и сенсибилизация организма, формирование
гиперчувствительности замедленного типа формируются бруцеллезные гранулемы.
18.
Процесс поглощения бруцелл и их высвобожденияиз депо многократно повторяется.
В дальнейшем бруцеллы вновь фагоцитируются, а
через некоторое время опять высвобождаются из
макрофагов и гематогенно распространяются по
организму.
Процесс поглощения бруцелл и их высвобождения
из фагоцитов многократно повторяется.
Поэтому течение болезни принимает характер
хрониосепсиса с периодическими рецидивами и
аллергизацией организма.
При таком течении болезни возбудитель
гематогенно заносится в лимфатические узлы,
печень, селезенку, костный мозг и другие органы
19. Клинические проявления
Продолжительность инкубационного периодасоставляет от 1 до 6 недель.
Начало заболевания постепенное. Больные
предъявляют жалобы на перемежающие боли в
суставах, преимущественно нижних конечностей,
длительную субфебрильную температуру тела,
резкую слабость и упадок сил.
Температура тела обычно повышается во второй
половине дня; падение температуры в ночное время
сопровождается обильным потоотделением
(ундулирующая лихорадка). Лихорадка
продолжается в течение месяцев.
20. Температурная кривая при бруцеллезе (ундулирующая лихорадка)
21. Клинические проявления
После острой фазы может развитьсяхроническая стадия.
Летальность при бруцеллезе до применения
антибиотиков составляла 8-15%, в настоящее
время - 0,1%.
Прогноз для жизни обычно благоприятный,
но длительное течение болезни и осложнения
приводят к утрате трудоспособности и
стойкой инвалидности.
22.
Лабораторная диагностика бруцеллезавключает бактериологические,
биологические, серологические и
аллергологические методы.
Бактериологический и биологический
методы проводятся в
специализированных лабораториях
особо опасных инфекций.
23. Лабораторная диагностика
Материал для исследований:от людей: кровь, моча, костный мозг,
спинномозговая жидкость, суставная жидкость
(при артритах), околоплодные воды,
секционный материал;
от животных: абортированные плоды,
плодные оболочки, лимфатические узлы;
пищевые продукты: молоко, сливки, сыры,
творог, мясо;
объекты внешней среды: почва, вода.
24.
Серологические реакции,направленные на выявление
антител:
реакция агглютинации на стекле
(реакция Хеддельсона);
развернутая реакция агглютинации
(реакция Райта);
ИФА (для выявления IgM при
остром бруцеллезе и IgG – при
хроническом бруцеллезе).
25.
Для постановки реакцийагглютинации Хеддельсона или
Райта используют единый
бруцеллезный диагностикум
26.
Кожно-аллергическая проба(проба Бюрне)
Иммунитет появляется у больных через 3-4
недели от начала заболевания и может
сохраняться годами после исчезновения
клинических симптомов
Бруцеллин - 0,1%-ный раствор
полисахаридно-белкового комплекса,
полученного из вакцинного штамма
B. abortus.
Положительная реакция Бюрне отмечается у
больных и вакцинированных лиц.
27. Профилактика неспецифическая
Комплекс мероприятий, проводимыхсовместно медицинскими и ветеринарными
специалистами:
защита людей от инфицирования;
специфическая вакцинопрофилактика у
животных;
профилактические осмотры лиц, занятых в
работах, связанных с риском инфицирования;
санитарно-просветительная работа.
28. Специфическая профилактика
Иммунизация живой вакциной лиц,связанных с риском
инфицирования.
Применяют живую сухую вакцину
из штамма В. abortus 19-ВА
29. Вакцина бруцеллезная
30.
Чума31.
Возбудитель чумыСемейство Yersiniaceae
Род Yersinia
Yersinia pestis
32.
Чума (лат. pestis — зараза) — остроеприродно-очаговое инфекционное
заболевание группы карантинных
инфекций, протекающее с
исключительно тяжёлым общим
состоянием, лихорадкой, поражением
лимфоузлов, внутренних органов, часто
с развитием сепсиса.
33. Три пандемии чумы
Первая пандемия - “Юстинианова чума” (531589 гг.). Название по имени византийскогоимператора Юстиниана. Пандемия началась в
Египте. Во время этой пандемии от чумы
погибло почти 100 млн. человек.
Вторая пандемия - “Черная смерть”, была
занесена из Монголии. В течение 1346-1353 гг.
от чумы погибло около 60 млн. человек, в том
числе более 25 млн. человек в Европе.
Третья пандемия возникла в 1855 г. в Китае и
в течение нескольких десятилетий
распространилась на все континенты.
Третья пандемия продолжалась до 1938 г.
34. Чума
35. Plague Doctor Mask
36.
37. Александр Йерсен и Шибасабуро Китазато
189438. Морфология
Палочка овоидной формыГрамотрицательная
Окрашивается биполярно
Неподвижная
Факультативный анаэроб
Спор не образует
Нетребовательны к питательным средам
39. Yersinia pestis окраска метиленовым синим по Лёффлеру
40. Yersinia pestis
41. Культуральные свойства
42. Культуральные свойства
43. Антигенное строение
О-антиген - эндотоксинF1-антиген - поверхностный
капсульный антиген
V/W -антиген состоит из белка
(V-фракция) и липопротеина (Wфракция)
44. Факторы патогенности
Пили - адгезияКапсула - защита от фагоцитоза
Эндотоксин
F1-антиген-поверхностный гликопротеин
(защита от фагоцитоза)
V-антиген белковой природы и W-антиген
проявляют антифагоцитарные свойства и
способствуют внутриклеточному размножению
бактерий
F2-фракция (мышиный токсин)–белковоподобное
вещество, вызывающее шок и гибель
лабораторных животных
Плазмокоагулаза
Нейраминидаза
45.
46.
47. Блоха – переносчик (чумной блок)
48.
49. Пути передачи
трансмиссивный (через переносчика)контактный (через не поврежденную
кожу)
алиментарный
воздушно-капельный
50. Патогенез чумы
Включает следующие стадии:• Проникновение возбудителя в организм в месте
укуса блохи.
• Фагоцитоз возбудителя и лимфогенный перенос
фагоцитированного возбудителя (незавершенный
фагоцитоз) от места проникновения до регионарных
лимфатических узлов (множественный
лимфаденит), размножение возбудителя в
регионарных лимфатических узлах, развитие
серозно-геморрагического воспаления,
формирование бубона (многократно увеличенного
лимфатического узла, достигающего размеров
куриного яйца). Так возникает первичная бубонная
форма.
51. Патогенез чумы
• Распространение возбудителя из пораженныхлимфатических узлов в кровоток (бактериемия),
гематогенное распространение возбудителя по
организму с поражением внутренних органов
(септицемия). Формирование вторичных очагов во
внутренних органах.
• Гематогенный занос чумных микробов в легкие
приводит к развитию вторично-легочной формы
заболевания, которая характеризуется развитием
пневмонии с обильным серозно-геморрагическим
экссудатом, содержащим большое число микробов.
52. Клиническая картина заболевания
Инкубационный период - от нескольких часов до 2-6дней.
Заболевание начинается остро: температура тела
повышается до 39°С и выше, возникает озноб,
резкая головная боль, разбитость, мышечные боли,
помрачение сознания.
Больной возбужден, наблюдается бессонница,
шатающаяся походка. Отмечается налет на языке
(“натертый мелом язык”), отек языка, в результате
чего речь больного становится невнятной.
Отмечаются множественные кровоизлияния в
кожных покровах и темные круги под глазами.
53. Клиническая картина заболевания
При бубонной форме на 1-2 день болезнипоявляется чумной бубон – многократно
увеличенный воспаленный лимфатический
узел, выступающий над поверхностью кожи.
Чаще всего поражаются бедренные и паховые
лимфатические узлы, реже – подмышечные и
шейные.
54. Бубон
55. Клинические формы
Локальныекожная,
кожно-бубонная,
бубонная
56. Клиническая картина заболевания
При массивном размножении возбудителя ворганизме больного вырабатывается большое
количество медиаторов воспаления.
Это приводит к развитию диссеминированного
внутрисосудистого свертывания (ДВС-синдрома),
при котором поражаются внутренние органы, и
развивается инфекционно-токсический шок,
приводящий к гибели больного.
Эта форма заболевания проявляется
кровоизлияниями под кожу, в слизистые оболочки,
кровотечением из почек, желудка и кишечника.
57. Симптомы септической формы чумы
58. Клинические формы
Генерализованныепервично-септическая,
вторично-септическая,
первично-легочная,
вторично-легочная,
кишечная
59. Лабораторная диагностика чумы
Чума является чрезвычайноконтагиозной, поэтому взятие материала
от больного (особенно легочной формы)
производится с соблюдением мер
предосторожности.
Работа проводится в полном
противочумном костюме.
60. Лабораторная диагностика чумы
Материалы:содержимое бубона (легочная форма чумы);
отделяемые язвы (кожная форма чумы);
материал из зева, взятый тампоном, и мокрота
(легочная форма чумы);
секционный материал (кусочки органов трупа,
кровь);
живые грызуны;
трупы грызунов;
блохи;
вода;
пищевые продукты.
61. Лабораторная диагностика чумы
1. Микроскопическое исследование (окраска поГраму);
2. Бактериологическое исследование
(фаготипирование);
3. Биологическая проба - обязательна при
исследовании ( морские свинки и белые мыши);
4. Ускоренные методы диагностики
(иммунофлюоресцентный метод);
5. Серологические реакции используются для
ретроспективного диагноза, при обследованиях
природных источников чумы.
62. Экспресс-диагностика чумы - реакция иммунофлюоресценции
63. Специфическая профилактика
Вакцина живая на основе штамма EV.Иммунизацию проводят однократно
подкожным, накожным, внутрикожным
или ингаляционным способами .
Ревакцинацию проводят через 12 мес.
Вакцинации подлежат дети с 2 лет и
взрослые, проживающие на энзоотичных по
чуме территориях, а также лица,
работающие с живыми культурами
возбудителя чумы.
64.
Энзоотичной считается территория(административный район), где в прошлом
были зарегистрированы местные случаи
заболевания людей, выделены культуры
возбудителя болезни или регулярно
выявлялся антиген возбудителя болезни в
объектах внешней среды (гнезда грызунов,
вода и т.д.).
65.
Туляремия66.
Туляремия –природно-очаговыйзооноз, протекающий с интоксикацией,
лихорадкой, развитием лимфаденита и
поражением различных органов.
Болезнь является сезонной, и
большинство случаев инфицирования
приходятся на лето и осень.
67. Классификация
Семейство: FrancisellaceaeРод: Francisella
Вид: F. tularensis
Еще 5 видов, непатогенных для
человека
68.
В 1912 г. американские бактериологиДжордж Мак-Кой и Чарльз Чепин с
противочумной станции, находящейся
вблизи озера Туляре в Калифорнии,
выделили возбудитель от больных
сусликов.
69.
Эдвард Фрэнсис(1872–1957)
В 1921 г. американский
бактериолог Эдвард Фрэнсис
установил возможность
передачи возбудителя
заболевания от грызунов
человеку контактным путем
и кровососущими
членистоногими.
Так возбудитель получил
название Francisella tularensis,
а заболевание получило
название туляремия.
70.
Семейство - FrancisellaceaeВозбудитель туляремии —
Francisella tularensis.
Американские бактериологи Джордж
Мак-Кой и Чарльз Чепин выделили
возбудитель в 1912 г. от больных
сусликов в местности Туляре.
71. Биологические свойства
мелкая, кокковидная палочканеподвижна, спор не образует, есть
капсула
грамотрицательная
аэробный микроорганизм
на простых питательных средах не растет
72. Культуральные свойства
Для получения чистой культурыисследуемый материал вводят в
организм чувствительного животного, а
потом делают посев на питательные
среды (с добавлением крови, экстрактов
органов), так как при первичном посеве
на питательные среды, выделить
возбудитель от человека не удаётся.
73. Основные факторы патогенности
Возбудителя туляремииявляются:
капсула;
белки внешней мембраны;
эндотоксин;
нейраминидаза.
74. Пути передачи
АлиментарныйВоздушно-пылевой
Трансмиссивный
Контактный
Контактно-бытовой
75.
Заражение происходит черезповрежденную и неповрежденную
кожу, слизистые оболочки верхних
дыхательных путей, глаз,
желудочно-кишечного тракта.
76. Патогенез
После того как бактерии попали в организм, они разносятсяс током лимфы по лимфатическим узлам.
Там они активно размножаются, стимулируя развитие
лимфаденита – увеличение лимфатических узлов (бубон).
Далее бактерии проникают в кровь, провоцируя развитие
бактериемии. Погибая, они выбрасывают в кровь большое
количество эндотоксина. Развивается фаза общей
интоксикации.
Вместе с током крови бактерии проникают во внутренние
органы, где вызывают поражение легких, печени,
селезенки.
Во внутренних органах бактерии формируют
туляремийные гранулемы.
77.
Клинические формы инфекции:бубонная,
язвенно-бубонная,
легочная,
абдоминальная,
генерализованная.
78. Клиника
Инкубационный период длится от трёх дней дотрёх недель, в среднем около семи суток.
Начало заболевания характеризуется резким
подъемом температуры до 39 0 С.
Конъюнктива глаз становится резко красной,
Появляется сыпь.
Все эти симптомы связаны с явлением общей
интоксикации и обусловлены действием
эндотоксина.
Основным специфическим симптомом этого
периода является регионарный лимфаденит.
79. Лабораторная диагностика
Используют:аллергический,
cерологический (ИФА - IgM/IgG),
биологический методы исследования
ПЦР
80. Лабораторная диагностика
Кожно-аллергическая проба с тулярином(взвесь убитых туляремийных
микроорганизмов) служит ранним методом
диагностики заболевания, так как бывает
положительна с 3—5-го дня болезни и
сохраняется годами.
Тулярин вводят внутрикожно на внутреннюю
поверхность предплечья. Положительная
реакция появляется через 24—28 ч.
Серологическим методом диагностики
туляремии является реакция агглютинации.
81. ПЦР-диагностика
Материал:отделяемое кожной язвы,
содержимое лимфоузлов при пункции,
мокрота ,
мазки с конъюнктивы, из ротоглотки,
испражнения,
кровиь.
82. Профилактика
• Вакцина туляремийная живая.• Препарат представляет собой живую культуру вакцинного
штамма Francisella tularensis 15.
• Вакцина предназначена для профилактики туляремии с 7
летнего возраста.
• Прививкам подлежит население, проживающее на
энзоотичных по туляремии территориях, а также
прибывшие на эти территории лица для выполнения
определенных работ (сельскохозяйственных, строительных,
заготовительных, промысловых, геологических,
дератизационных и дезинсекционных, по лесозаготовке,
расчистке и благоустройству леса, зон оздоровления и
отдыха населения).
• Вакцинацию проводят однократно накожно или
внутрикожно.
• Ревакцинацию проводят по показаниям через 5 лет.
83.
• Контроль по разделу«Частная бактериология».
• Возбудители ОРВИ. Риновирусы. Вирусы
гриппа. Респираторно-синцитиальный
вирус. Вирусы парагриппа. Аденовирусы.
Коронавирусы.

medicine
medicine








